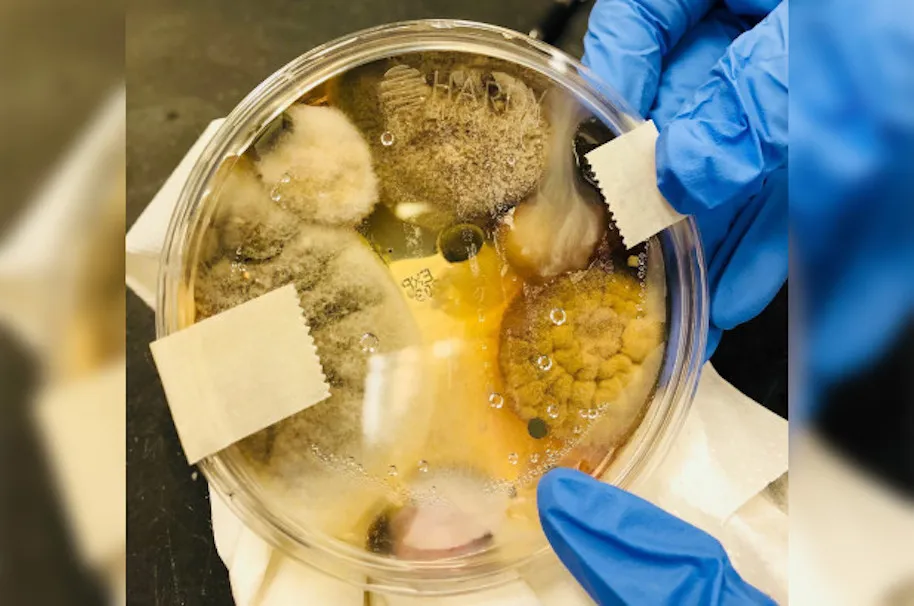

Photo: markp73 (Getty)
I didn’t mean to yell, but after seeing this Facebook post that is going around, I think it’s urgent that we tell you al that it’s probably best to dry your hands on the jeans that you never wash instead of using a hand dryer.
Nichole Ward, of California, decided to take it to Facebook to show a Petri dish that she enclosed inside of a hand dryer of a public bathroom for a few days in order to see what would occur. And well, let’s just say that what ended up on that Petri dish afterwards was something that looks like it came out of a sci-fi film.
I think you all deserve a a closer look at this horror show:
Here’s what Ward had to say on Facebook:
“I stuck the open plate in an enclosed hand dryer of a public bathroom for a total of 3 minutes. Yes 3 only. DO NOT EVER dry your hands in those things again. This is the several strains of possible pathogenic fungi and bacteria that you’re swirling around your hands, and you think you’re walking out with clean hands. You’re welcome. ”
Well that’s gross.
According to Ward, she used the Dyson Airblade and then “incubated” it for 48 hours. A Dyson spokesperson of course chimed in and said this:
“We’re very surprised to see these results, and unclear on the methodology employed. All Dyson AirbladeTM hand dryers have HEPA filters that capture particles as small as bacteria from the washroom air before it leaves the machine. Dyson AirbladeTM hand dryers are proven hygienic by university research and are trusted by hospitals, food manufacturers and businesses worldwide.”
If I’m being honest, I’ve never really trusted those hand dryers, especially the ones you just place both hands in as the air forces your hands to touch the device anyway. You can’t win these days, it seems. We are all just filthy, germ-filled monsters.
h/t NY Post